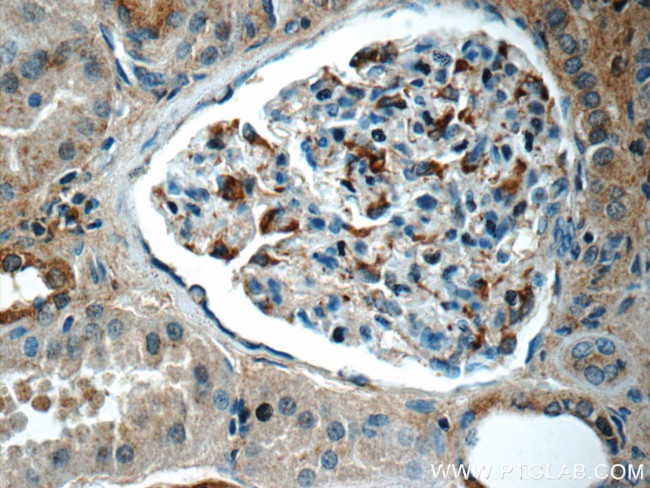
SNCAIP Antibody in Immunohistochemistry (Paraffin) (IHC (P))
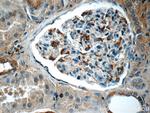
SNCAIP Antibody in Immunohistochemistry (Paraffin) (IHC (P))
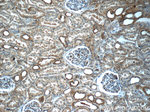
SNCAIP Antibody in Immunohistochemistry (Paraffin) (IHC (P))

Search
Proteintech
SNCAIP Polyclonal Antibody
{{$productOrderCtrl.translations['antibody.pdp.commerceCard.promotion.promotions']}}
{{$productOrderCtrl.translations['antibody.pdp.commerceCard.promotion.viewpromo']}}
{{$productOrderCtrl.translations['antibody.pdp.commerceCard.promotion.promocode']}}: {{promo.promoCode}} {{promo.promoTitle}} {{promo.promoDescription}}. {{$productOrderCtrl.translations['antibody.pdp.commerceCard.promotion.learnmore']}}
产品信息
17818-1-AP
种属反应
已发表种属
宿主/亚型
分类
类型
抗原
偶联物
形式
浓度
规格
纯化类型
保存液
内含物
保存条件
运输条件
产品详细信息
Immunogen sequence: ILRQLLGKE ISENVCTQEK LSLEFQDAQA SSRNSKKIPL EKRELKLARL RQLMQRSLSE SDTDSNNSED PKTTPVRKAD RPRPQPIVES VESMGSAESL HLMIKKHTLA SGGRRFPFSI KASKSLDGHS PSPTSESSEP DLESQYPGSG SIPPNQPSGD PQQPSPDSTA AQKVATSPKS ALKSPSSKRR TSQNLKLRVT FEEPVVQMEQ PSLELNGEKD KDKGRTLQRT STSNESGDQL KRPFGAFRSI METLSGNQNN NNNYQAANQL KTSTLPLTSL GRKTDAKGNP ASSASKGKNK AEMYSSCINL SSNMLIEEHL CNDTRHNDIN RKMKKSYSIK HIAEPESKEL FL (253-603 aa encoded by BC094759)
靶标信息
Parkinson is the second most common neurodegenerative disease after Alzheimer's. About 1 percent of people over the age of 65 and 3 percent of people over the age of 75 are affected by the disease. The mutation is the most common cause of Parkinson disease identified to date. Synuclein alpha interacting protein (Synphilin-1) contains several protein-protein interaction domains and interacts with alpha synuclein in neurons. Mutations of SNCAIP have been linked to Parkinson disease. The amino acid sequence of synphilin-1 shows extensive homology with its human counterpart, especially in regions containing ankyrin-like motifs and the coiled-coil domain. Expression of mouse synphilin-1 in tissues is similar to its human counterpart. Synphilin-1 has an important role in the formation of aggregates and cytotoxicity in Parkinson disease and that Dorfin may be involved in the pathogenic process by ubiquitylation of synphilin-1. Role of synphilin-1 in synaptic function and protein degradation and in the molecular mechanisms leading to neurodegeneration in Parkinson disease.
仅用于科研。不用于诊断过程。未经明确授权不得转售。
生物信息学
蛋白别名: Alpha-synuclein-interacting protein; MGC39814; Sph1; Synphilin 1; Synphilin-1; unnamed protein product
基因别名: 2810407O15Rik; 4933427B05Rik; BB104594; SNCAIP; Sph1; SYPH1
UniProt ID: (Human) Q9Y6H5, (Mouse) Q99ME3
Entrez Gene ID: (Human) 9627, (Mouse) 67847